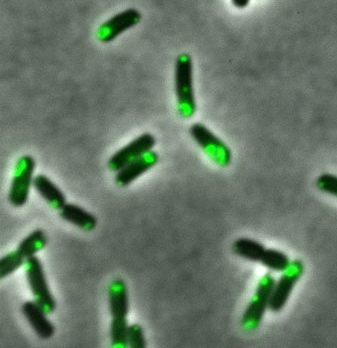

We are turning biology from a game of chance into a discipline of engineering, unleashing immense potential — from curing disease to biological computation.

We engineer novel cellular structures using self-assembly principles. Our flagship breakthrough, Synthetic Organelles, allows us to compartmentalize reactions inside prokaryotes, mimicking complex eukaryotic functions.

We develop the compilers and syntax for biological code. By defining the rules of genetic logic, we create programmable genetic circuits that perform reliably across diverse applications.

We are closing the loop between silicon and carbon. Rather than merely applying AI to existing workflows, we focus on workflows where AI and biological programs collaborate organically, enabling the exploration of infinite design spaces.
Explore our programmed biology in action.
This work, originating from the 2017 iGEM Paris Bettencourt Project, reported the first demonstration of engineered liquid-liquid phase separation (LLPS) in bacteria. Published in Cell (2022), it includes comprehensive characterization from foundational research to metabolic engineering applications.

A first look at the data, protocol, and in-cell performance of the PandaPure system for tag-free protein purification, and its application in industrially-relevant proteins.

How can AI help combat the global crisis of antimicrobial resistance? Discover how advanced nanobot and AMP design offers a new approach.

We work with academic and industry partners who share our passion for pushing the boundaries of biological programming.